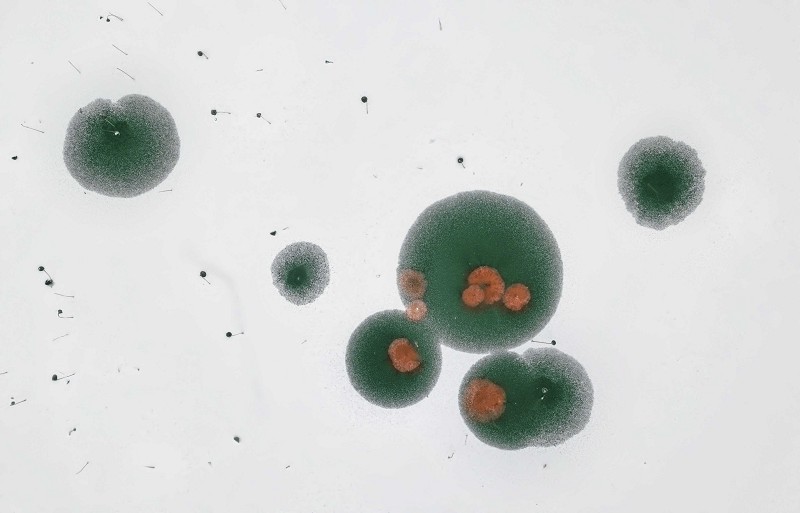

古城飞雪——摄于仲宣楼陈涛摄
冰上雪痕——摄于隆中 陈涛 摄

雾凇美景醉游人——摄于保康县后坪镇 杨韬 摄

冬日甜点——摄于保康县后坪镇 杨韬 摄

丽人行 花葵 摄
12月7日,正值农历大雪节气,雪花如约而至襄阳,南漳、保康、谷城等山区均有明显降雪,我市保康等地的摄影师们纷纷闻雪而动,拍摄到不少精美照片。而与山区“白花花”的景象相比,市区的雪花星星点点地表现了一下就无踪影。本报从“最美四十·飞阅襄阳”参赛作品中挑选出去年的一组城区雪景照片,为大家留下美的记忆。“最美四十·飞阅襄阳”庆祝改革开放40周年影像展示系列活动参展作品,以四季变幻为主线,征集市民拍到的表现襄阳发展、见证襄阳历史变迁的航拍作品。旨在展示襄阳改革开放40年的城市发展、经济社会、交通运输、生态文明建设、旅游产业等方面的城市发展巨变,征稿结束后将评选出年度最佳作品金、银、铜奖各一名,奖金丰厚,欢迎广大航拍爱好者踊跃投稿。
电子稿件作品发送至邮箱:409498297@qq.com,联系人:王虎






